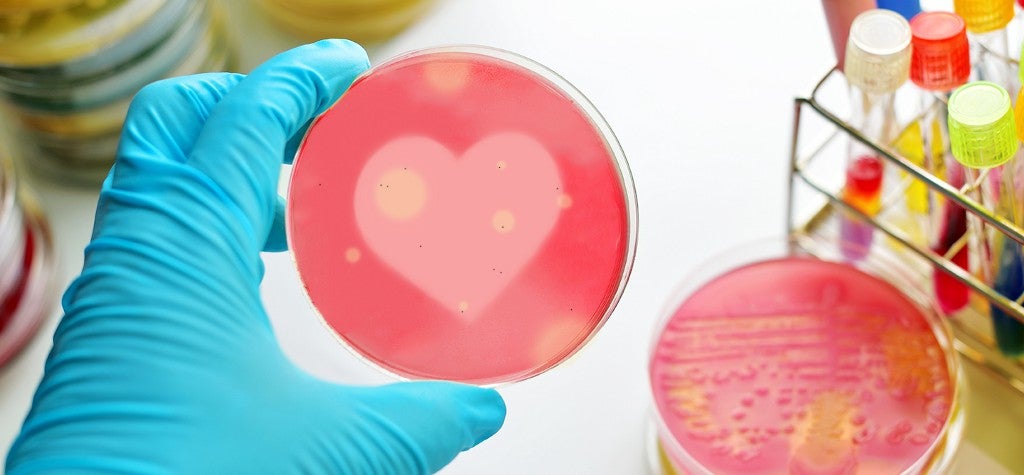

devon maloney
- 23
Recent
We Get It: Immortality Is Overrated
‘Dr. Strange’ is proof that forever escaping death is a total bore
MEL Presents: Twitter’s Best #DebateNight Analogy Awards
From ‘The Office’ to ‘The Real Housewives’, politics have never felt so surreal